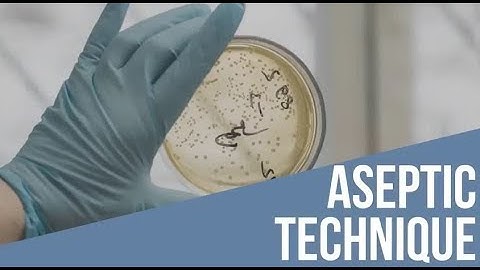
Aseptic Technique Streak for Isolation

⬇ DOWNLOAD NOW
Kalau muncul iklan pop-up, tutup lalu klik tombol kembali
Download lagu Fundamentals of Aseptic Technique-Lesson 5-Isolation secara gratis hanya untuk keperluan promosi. Dukung artis favorit kamu dengan membeli musik original di iTunes atau platform resmi lainnya.
 Aseptic Technique
Aseptic Technique
 Fundamentals of Aseptic Technique-Lesson 2-PPE
Fundamentals of Aseptic Technique-Lesson 2-PPE
 Fundamentals of Aseptic Technique-Lesson 1-Hand Hygiene
Fundamentals of Aseptic Technique-Lesson 1-Hand Hygiene
 Fundamentals of Aseptic Technique-Lesson 3-4-Patient-Staff
Fundamentals of Aseptic Technique-Lesson 3-4-Patient-Staff
 Aseptic Technique
Aseptic Technique
 Lab 1-3: Aseptic technique
Lab 1-3: Aseptic technique
 Fundamentals of Aseptic Technique-Lesson 14-Drying & Storage
Fundamentals of Aseptic Technique-Lesson 14-Drying & Storage
Aseptic Technique Streak for Isolation
Aseptic Technique Streak for Isolation